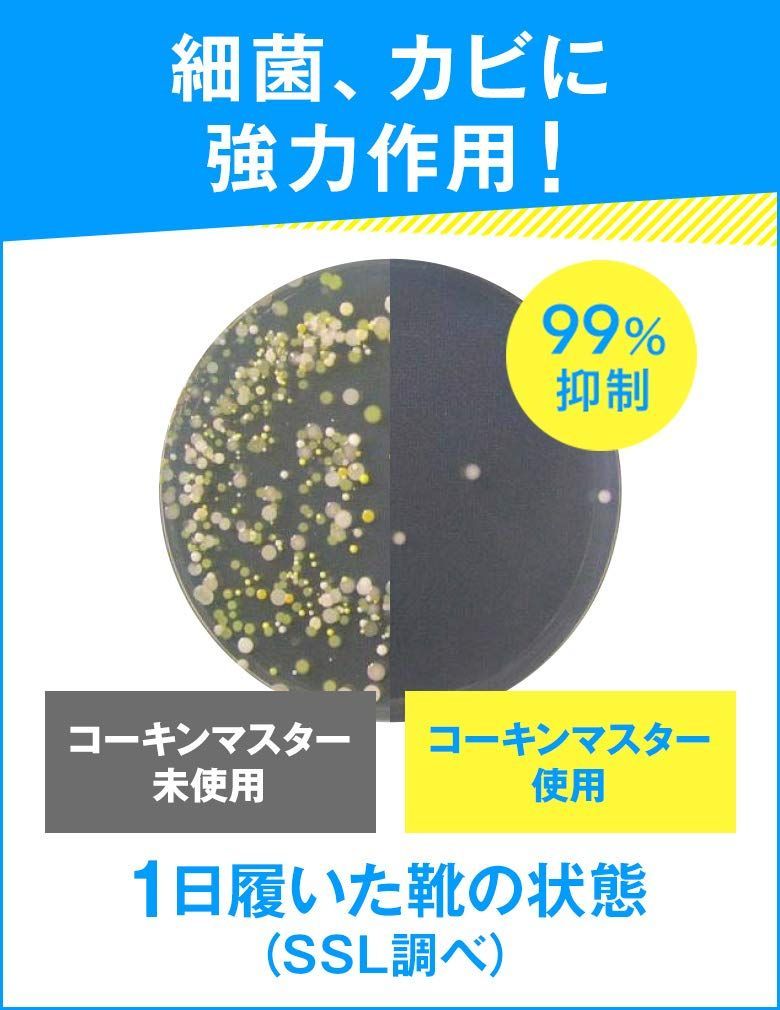
マフラー 売切注意 お急ぎ下さい 1足分 2枚入 男女兼用フリーサイズ インソール 強力消臭 抗菌 ドクターショール 店内全品大特価!!

マイストア
変更
お店で受け取る
(送料無料)
配送する
納期目安:
08月02日頃のお届け予定です。
決済方法が、クレジット、代金引換の場合に限ります。その他の決済方法の場合はこちらをご確認ください。
※土・日・祝日の注文の場合や在庫状況によって、商品のお届けにお時間をいただく場合がございます。
マフラー 売切注意 お急ぎ下さい 1足分 2枚入 男女兼用フリーサイズ インソール 強力消臭 抗菌 ドクターショール 店内全品大特価!!の詳細情報
ご覧いただきありがとうございます。
当店では他サイトにも商品を販売しているため
まれに売り切れや取り寄せ中となる場合がありますがご了承ください。
ドクターショール 強力消臭・抗菌 インソール 男女兼用フリーサイズ 1足分(2枚入)
世界100カ国以上で愛用されているフットケア専門ブランド、ドクターショール。
インソールで靴の中を快適に整え、歩行の痛みや臭いやムレを予防
抗菌・抗カビ成分コーキンマスター(R)が372種類もの菌に効果を発揮
消臭素材クリーンガード(R)が悪臭を強力に吸着・中和
ビジネスシューズに最適。営業や外回りなど、たくさん歩く方におすすめです
天然由来の消臭成分「クリーンガード(R)」が悪臭を強力に吸着・中和
さらに抗菌・防カビ成分「コーキンマスター(R)」が、372種類ものニオイの原因菌に効果を発揮し、再繁殖を阻止します
消臭+ニオイ菌の繁殖阻止によって消臭効果が長持ち
最後までご確認頂き誠にありがとうございました。
上記をご確認頂き、ご購入いただけましたら幸いです。
何かご不明な点がございましたらお気軽にメッセージからお問い合わせ下さい。
当店では他サイトにも商品を販売しているため
まれに売り切れや取り寄せ中となる場合がありますがご了承ください。
ドクターショール 強力消臭・抗菌 インソール 男女兼用フリーサイズ 1足分(2枚入)
世界100カ国以上で愛用されているフットケア専門ブランド、ドクターショール。
インソールで靴の中を快適に整え、歩行の痛みや臭いやムレを予防
抗菌・抗カビ成分コーキンマスター(R)が372種類もの菌に効果を発揮
消臭素材クリーンガード(R)が悪臭を強力に吸着・中和
ビジネスシューズに最適。営業や外回りなど、たくさん歩く方におすすめです
天然由来の消臭成分「クリーンガード(R)」が悪臭を強力に吸着・中和
さらに抗菌・防カビ成分「コーキンマスター(R)」が、372種類ものニオイの原因菌に効果を発揮し、再繁殖を阻止します
消臭+ニオイ菌の繁殖阻止によって消臭効果が長持ち
最後までご確認頂き誠にありがとうございました。
上記をご確認頂き、ご購入いただけましたら幸いです。
何かご不明な点がございましたらお気軽にメッセージからお問い合わせ下さい。
カテゴリー:
車・バイク・自転車##自転車##ウェア##シューズアクセサリー##インソール
商品の状態:
新品、未使用
配送料の負担:
送料無料
配送の方法:
未定(出品者が手配)
発送元の地域:
徳島県
発送までの日数:
2~5日
ベストセラーランキングです
近くの売り場の商品
カスタマーレビュー
オススメ度 4.4点
現在、4744件のレビューが投稿されています。

































